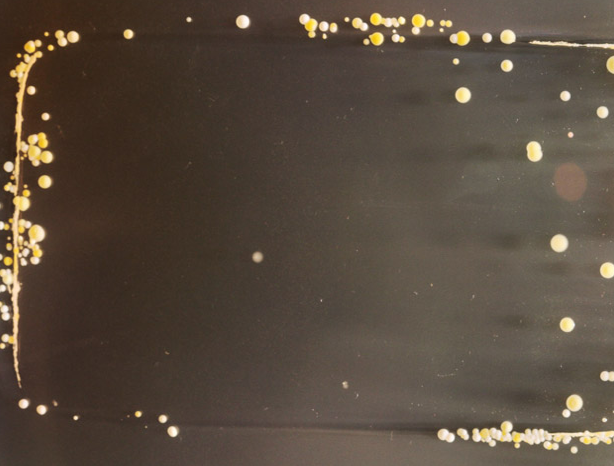
Telefonunuzdaki bu yaratığa dikkat edin! - Resim: 2
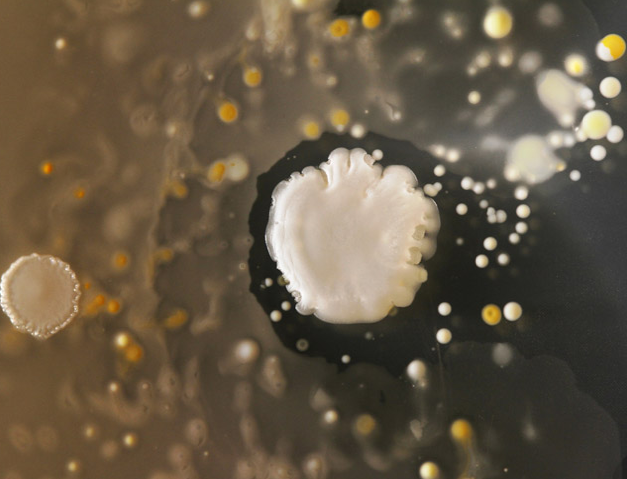
Telefonunuzdaki bu yaratığa dikkat edin! - Resim: 4

Telefonunuzdaki bu yaratığa dikkat edin!

Akıllı telefonlara yakından bakan bilim insanları bazı bakterilerin yaşadığını farketti

Akıllı telefonlara yakından bakan bilim insanları bazı bakterilerin yaşadığını farketti. Bu bakterilerden gıda zehri içerenler de var. Tuvaletlere oranla daha fazla bakteri taşıyan akıllı telefonlar için temizlik çözümleri de var.
Sanat çalışması gibi görünen bu fotograf aslında bir bakteriye ait. Bilim insanlarının "akıllı telefon bakterileri" olarak adlandırdığı bu canlılar, bizimle sürekli içiçe.

İngiltere'deki Surrey Üniversitesi Mikrobiyoloji bölümü öğrencileri cep telefonlarına yakından bakmaya karar verince bakterileri farkettiler. İnanması zor ama cep telefonlarında tuvaletin 18 katı daha fazla bakteri bulundu.
Öğrenciler, bakterileri laboratuvarlarda ürettiler ve geliştirdiler. Cep telefonunu bakteri üretme kaplarına koyan öğrenciler, 3 gün sonra bu garip yaratıkları görüntülediler.